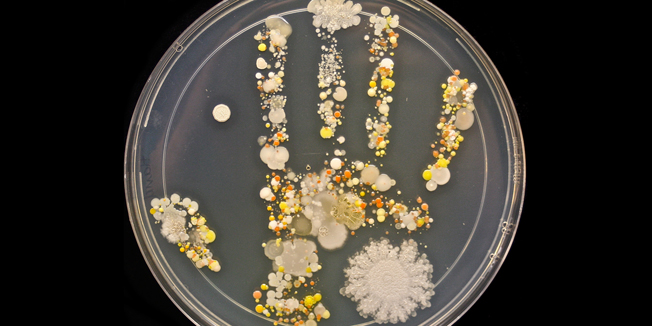
848321.bin

Koliko se bakterija skriva na rukama djece nakon igre izvan kuće? Tasha Sturm odlučila je demonstrirati zornim primjerom - uzela je otisak dlana svojeg 8-godišnjeg sina na sterilnu Petrijevu posudicu, koju je potom inkubirala 24 sata u inkubatoru na 37°C. Nakon što je ostavila posudicu još par sati na sobnoj temperaturi, dobila je zanimljiv kolaž bakterijskih kultura koje savršeno ocrtavaju otisak dlana njezinog djeteta.
Iako rezultat izgleda dosta jezivo, potpuno je normalno da su naši dlanovi prekriveni bakterijama - izloženost sigurnim količinama i vrstama bakterija nužna je za razvoj zdravog mikrobioma, imunosustava i zdrave probave. Ž

Za sudjelovanje u komentarima je potrebna prijava, odnosno registracija ako još nemaš korisnički profil....